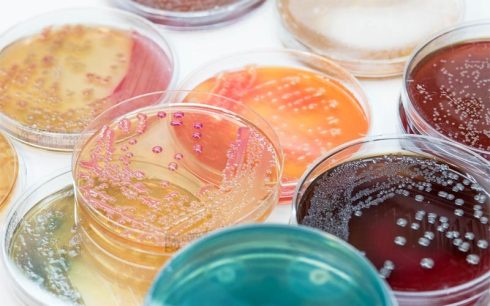
انواع محیط کشت در میکروبیولوژی و نحوه تهیه آن‌ها

آرشیو دسته بندی: ویکی ژن
تکنیک استخراج RNA
تکنیک استخراج RNA، خالص سازی RNA از نمونه های بیولوژیکی است. این روش با حضور[بیشتر بخوانید]
اصلاح پس از رونویسی در زیست شناسی
اصلاح پس از رونویسی در زیست شناسی به این مفهوم در ویدئوهای متعددی اشاره[بیشتر بخوانید]
تفاوت پروکاریوت و یوکاریوت: 47 تفاوت کلیدی
جدول تفاوت پروکاریوت و یوکاریوت S.N. خصوصیات پروکاریوتها یوکاریوتها 1. ریشه واژه یونانی نوکلئوس[بیشتر بخوانید]
9 دیدگاه
انواع میکروسکوپ
در این ویدئو ما به دنبال تفاوت های انواع میکروسکوپ ها هستیم و بعدا[بیشتر بخوانید]
نحوه تکثیر DNA
نحوه تکثیر DNA ما در مورد DNA بسیار صحبت کرده ایم، در واقع هدایت[بیشتر بخوانید]
2 دیدگاه
آنتی بادی ها چه هستند؟
آنتی بادی ها چیستند؟ اگر اولین بارتان هست که در مورد آنتی بادی ها می[بیشتر بخوانید]
تکنیک ARMS PCR
تکنیک ARMS PCR سیستم جهشی مقاوم به تکثیر (ARMS) کاربردی از PCR است که در[بیشتر بخوانید]
نحوه ساختار و عملکرد DNA
نحوه ساختار و عملکرد DNA در این ویدئو در مورد ساختار و عملکرد DNA[بیشتر بخوانید]
تکنیک ایمونوسیتوشیمی ICC
تکنیک ایمونوسیتوشیمی ICC تکنیک ایمونوسیتوشیمی ICC یک تکنیک آزمایشگاهی رایج است که برای تجسم آناتومیکی[بیشتر بخوانید]
4 دیدگاه
تکنیک RFLP در PCR چیست؟ اصول و کاربردها
تکنیک RFLP در PCR تکنیک RFLP در سال 1984 توسط دانشمند انگلیسی الک جفریس (Alec[بیشتر بخوانید]
تست MBC در میکروبیولوژی: مراحل انجام و کاربرد
مقدمهای بر تست MBC در میکروبیولوژی آزمایش حداقل غلظت کشنده باکتری (MBC) یک آزمایش میکروبیولوژی[بیشتر بخوانید]
نحوه استخراج ژنوم باکتری
استخراج ژنوم باکتری باکتری شناسی به بخش جدایی ناپذیر از علم زیست شناسی مولکولی تبدیل[بیشتر بخوانید]
7 دیدگاه
تکنیک MIC: مراحل، روشهای انجام، کاربرد و تفسیر نتایج
تکنیک MIC چیست؟ در علم میکروبیولوژی، غلظت مهارکنندگی حداقل که تحت عنوان تست MIC شناخته[بیشتر بخوانید]
تکنیک کلنی کانت
کلنی کانت چیست؟ تکنیک کلنی کانت شمارش سلول ها یا کلنی کانت یکی[بیشتر بخوانید]
تکنیک Nested PCR
واکنش زنجیره ای پلیمراز تودرتو (nested PCR) واکنش زنجیره ای پلیمراز تو در تو ([بیشتر بخوانید]
سلول های تخصص یافته چیستند؟ به همراه ویدیو آموزشی
زمانی که به سلول های تخصص یافته فکر می کنید، دقیقا به چه چیزی از[بیشتر بخوانید]
انواع محیط کشت در میکروبیولوژی و نحوه تهیه آنها
مقدمهای بر انواع محیط کشت در میکروبیولوژی و نحوه تهیه آنها محیط کشت در میکروبیولوژی[بیشتر بخوانید]
آموزش Transcription در ژنتیک مولکولی
رونویسی و ترجمه در این ویدیو یک نگاه اجمالی بر رونویسی و ترجمه در[بیشتر بخوانید]
3 دیدگاه
آکریل آمید چیست؟
مقدمهای بر آکریل آمید در ژوئن سال 2015، EFSA (European Food Safety Authority) به دنبال[بیشتر بخوانید]
راهنمای خرید فلاسک کشت سلولی: انواع و کاربردها
فلاسک کشت سلولی چیست؟ فلاسک کشت سلولی نوعی ظرف آزمایشگاهی است که به طور ویژه[بیشتر بخوانید]
2 دیدگاه